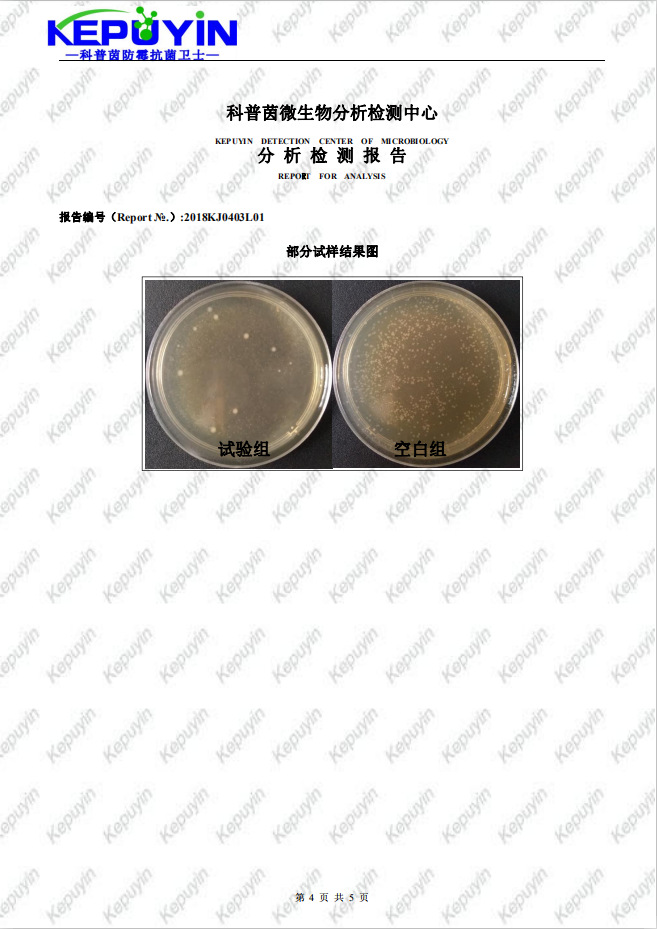
undefined

发泡材料抗菌剂 海绵发泡鞋垫聚氨酯防霉抗菌 应用
- 供应商
- 佛山科普茵生物科技有限公司
- 认证
- 品牌
- 科普茵
- 型号
- KEPUYIN-J22
- 产地
- 广东
- 联系电话
- 0757-88788686
- 手机号
- 18620907734
- 经理
- 陈师
- 所在地
- 佛山市南海区大沥镇盐步横江横沙路88号厂房的2楼(住所申报)
- 更新时间
- 2021-10-22 11:03


发泡材料液体抗菌剂KEPUYIN-J22属于环保塑料抗菌剂,保护塑料制品免遭细菌的侵蚀。外观为无色透明液体,其耐温性可达280℃。本品具有广谱抑菌作用,对常见的细菌、霉菌、酵母菌、藻类都有显著的抑制作用,目前已广泛应用于软质聚氯乙烯和聚氨酯工业、塑料、橡胶、电线电缆、电子元件等材料中。


*抗菌性能优异、杀菌广谱,尤其对细菌、酵母、霉菌、藻类等有效;
*与大多数工业产品相容性良好,分散均匀,易于运输,使用方便;
*产品安全环保,不含重金属,对人体刺激性小,符合欧盟相关法规;
*可耐温280℃,化学性质稳定,耐雨淋、耐紫外,优良的耐候性;
*与大多数多聚物配方体系相容,不改变基体的颜色和其它物理化学性质。


添加到PU/TPU/TPR/TPE/EVA/PVC等软质塑料制品、PP/PE/PET塑料制品、涂料或胶水涂饰剂、油墨、纸张、电缆等内搅拌均匀后工艺不变,即可成防霉抗菌制品。

※如聚氯乙烯、聚醋酸乙烯、聚乙烯、聚氨酯树脂、酚醛树脂等加工过程中,添加0.3~0.8%的量,即可制成防霉制品。
※如胶黏剂、硅酮胶、涂料等加工过程中,添加0.5~1.2%的量,即可制成防霉制品。

发泡材料液体抗菌剂KEPUYIN-J22主要成分为中的活性组分具有表面活性特性,有助于溶解微生物细胞膜,导致细胞损伤并Zui终导致微生物死亡。辅助成分与微生物细胞中酶的巯基(SH)配位结合,从而阻止微生物的代谢、杀灭细胞或孢子。当主要成分与辅助成分组合使用时,具有表面活性剂的主要成分有助于使微生物细胞壁更容易被辅助成分接触。
*QB/T2591-2003 抗菌塑料-抗菌性能试验方法和抗菌效果,附录A:抗菌塑料-抗细菌性能试验方法
* GB/T1741-2007漆膜耐霉菌性测定法
* GB/T21866-2008 抗菌涂料(漆膜)抗菌性测定法和抗菌效果
* AATCC100-2004 纺织材料抗菌整理剂的评定
* JIS L1902-2008 纺织品抗菌性能的检测与评价

注意事项
使用操作时必须戴手套、防护口罩和护目镜,避免接触皮肤。一旦大量吸入和眼睛接触立即用大量清水及肥皂清洗并及时就医。
包装储存
包装及规格:化工纸装,25kg/桶。密封储存,避免吸潮后不易分散。







